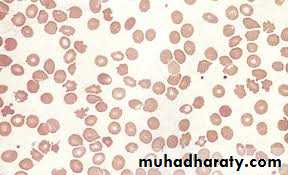
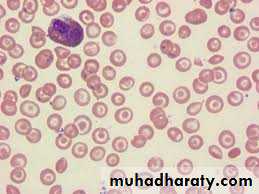
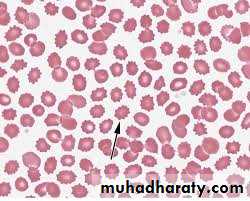

Anaemia of chronic disorders (ACD)
byDr. Teeb M. Jaafar
MBCh.B / F.I.C.M.S. (Path)
Anaemia of chronic disorders (ACD)
Many of the anaemias seen in clinical practice occur in patients with systemic disorders and are the result of a number of contributing factors. The anaemia of chronic disorders (ACD) is of central importance and occurs in patients with a variety of chronic inflammatory and malignant diseases .
Usually, both the erythrocyte sedimentation rate (ESR) and C‐reactive protein (CRP) are raised. It may be complicated by additional haematological changes due to the disease.
Causes
Causes of anaemia of chronic disorders:Chronic inflammatory diseases
Infectious (e.g. pulmonary abscess, tuberculosis, osteomyelitis, pneumonia, bacterial endocarditis)Non‐infectious (e.g. rheumatoid arthritis, systemic lupus erythematosus and other connective tissue diseases, sarcoid, Crohn’s disease, cirrhosis)
Malignant disease
(e.g. carcinoma, lymphoma, sarcoma, myeloma)
Pathogenesis
The pathogenesis of this anaemia appears to be related to :decreased release of iron from macrophages to plasma because of raised serum hepcidin levels. Hepcidin is a polypeptide produced by liver cells. It is the major hormonal regulator of iron homeostasis. It inhibits iron release from macrophages and from intestinal epithelial cells by its interaction with the transmembrane iron exporter, ferroportin. It accelerates degradation of ferroportin mRNA. Raised hepcidin levels therefore profoundly affect iron metabolism by reducing its absorption and release from macrophages. ( When iron stores are adequate or high, increased hepcidin expression inhibits intestinal iron absorption, release of recycled iron from macrophages and its transport across the placenta ). Hepcidin synthesis is increased by transferrin saturation and inflammation but reduced by increased erythropoiesis, erythropoietin, hypoxia and matriptase
reduced red cell lifespan.
an inadequate erythropoietin response to anaemia caused by the effects of cytokines such as IL‐1 and tumour necrosis factor (TNF) on erythropoiesis.
Lab. Findings
The characteristic features are:1. Normochromic, normocytic or mildly hypochromic (MCV rarely <75 fL) indices and red cell morphology.
2. Mild and non‐progressive anaemia (haemoglobin rarely <90 g/L) – the severity being related to the severity of the disease.
3. Both the serum iron and TIBC are reduced.
4. The serum ferritin is normal or raised.
5. Bone marrow storage (reticuloendothelial) iron is normal but erythroblast iron is reduced.
Summary:
• MCV/ MCH :Normal or mild reduction .
• Serum iron : Reduced .
• TIBC : Reduced .
• Serum ferritin : Normal or raised .
• Bone marrow iron stores : present.
• Erythroblast iron : Absent .
• Haemoglobin electrophoresis : normal.
Peripheral blood film in chronic renal failure showing red cell acanthocytosis and numerous ‘burr’ cells.
Liver disease: peripheral blood film showing: macrocytosis and target cells; and marked acanthocytosis and echinocytosis
CRP and ESR
The inflammatory response to tissue injury includes changes in plasma concentrations of proteins known as acute phase proteins. These include fibrinogen, other clotting factors, complement components, CRP, haptoglobin, serum amyloid A (SAA) protein, ferritin and others.The acute phase response is mediated by cytokines (e.g. IL‐1and TNF) released from macrophages and other cells. Quantitative measurements of acute phase proteins are valuable indicators of the presence and extent of inflammation and of its response to treatment.
When short‐term (less than 24 hours) changes in the inflammatory response are expected, CRP is the test of choice .
Long‐term changes in the acute phase proteins are monitored by either the ESR or plasma viscosity. These tests are influenced by plasma proteins, which are either slowly responding acute phase reactants (e.g. fibrinogen) or are not acute phase proteins (e.g. immunoglobulins).
Advantages and disadvantages of CRP and ESR
CRP
Advantages:
Specific test of acute phase protein
Fast response (6 hours) to change in disease activity
High sensitivity – owing to large incremental change
Can be measured on stored serum
Small sample volumes
Automated analysis
Disadvantages:
More than one protein required to measure acute (CRP) and chronic inflammation
Costly when assayed in small numbers
Sophisticated equipment and antisera required
ESR
Advantages:Useful in chronic disease
inexpensive,
easy,
no electrical power required
Disadvantages:
Not sensitive to acute changes (<24 hours)
Not specific for acute phase response
Slow to change with alteration in disease activity
insensitive to small changes in activity
Fresh samples (<2 hours) required for ESR